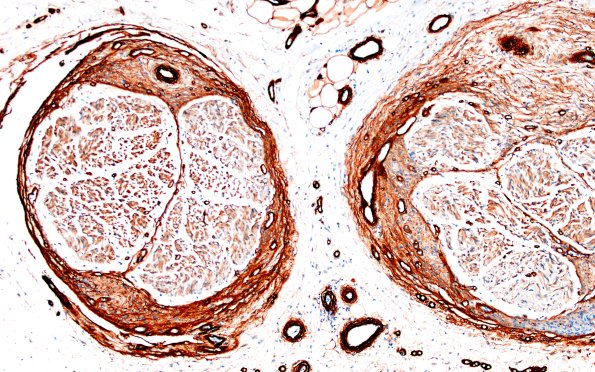
25E2 Nerve Trauma (Case 25) Coll IV 10X 1a

Table of Contents
Washington University Experience | PERIPHERAL NEUROPATHY | 19 TRAUMATIC INJURIES | 25E2 Nerve Trauma (Case 25) Coll IV 10X 1a
25E2-5 The perineurium stains strongly with collagen IV in a lamellar pattern. These cells are S100 negative and collagen type IV positive, indicating that they are perineurial cells. (Coll IV IHC)